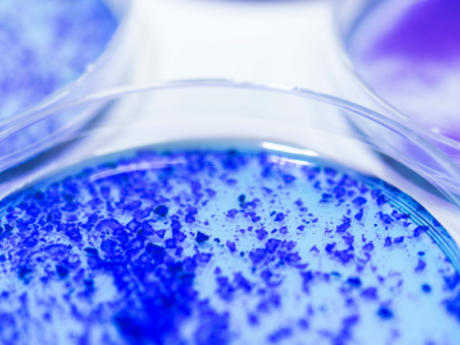

Galderma is committed to supporting the medical community and advancing the science of skin health to address patients' needs. We do this through a variety of mechanisms, including the support of various organizations in the form of commercial sponsorships, corporate donations, and charitable contributions. We also provide medical grants that support activities for healthcare professionals such as continuing education programs, clinical research activities, and residency program training programs.
DONATIONS & CHARITABLE CONTRIBUTIONS

Donations and contributions to tax exempt organizations for charitable, educational, and health-related causes
INDEPENDENT MEDICAL EDUCATION

Medical education grants to support independent accredited or non-accredited educational activities
INVESTIGATOR-INITIATED TRIALS
Research grants (funding or in-kind product) for academic and community-based clinician-scientists to conduct independent investigator initiated clinical trials.
RESIDENT TRAINING

In-kind product grants to support independent on-label injection trainings at ACGME-accredited dermatology, plastic surgery, ophthalmology, or otolaryngology residency programs.
SPONSORSHIP & EXHIBITS

Commercial support for educational conferences and professional meetings or trade show exhibit fees.